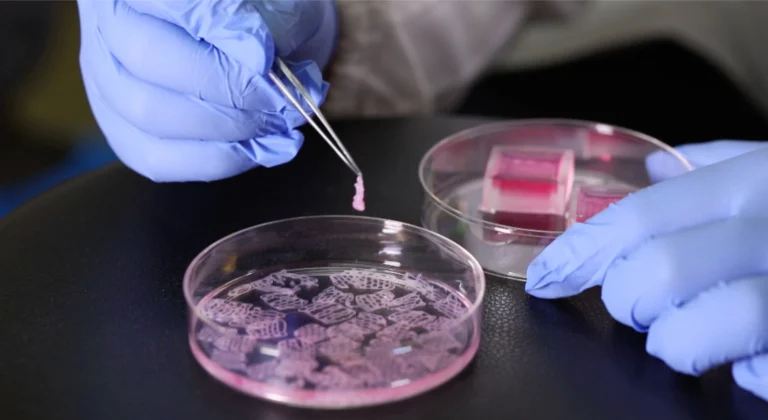

Industrial waste gas is one of the primary sources of air pollution, especially in sectors like chemical manufacturing, pharmaceuticals, and electronics. Among various treatment technologies, activated carbon has emerged as a highly effective solution due to its excellent adsorption properties and customizable forms.
Why Activated Carbon?
Activated carbon is known for its porous structure, large surface area, and high adsorption capacity, making it ideal for capturing volatile organic compounds (VOCs), odors, and hazardous gases. It’s especially effective in processes involving benzene, formaldehyde, toluene, and other industrial pollutants.
Applications Across Industries
In chemical plants, it is used in tail gas recovery systems. In pharmaceutical manufacturing, activated carbon helps remove odor-causing molecules and prevents harmful emissions. Municipal waste management centers use it for deodorization, while electronics factories apply it for cleanroom air purification.
Honeycomb & Columnar Carbon Advantages
Clarkson Carbon provides multiple types of activated carbon including CLKS600/700 honeycomb carbon and CC800-1500 columnar carbon. These are engineered for high surface contact, easy installation, and long operational life.
With increasing environmental regulations and growing awareness of sustainability, activated carbon will continue to play a key role in industrial air purification. Clarkson Carbon’s advanced materials and technical support make it a reliable partner for environmental compliance and cleaner production.